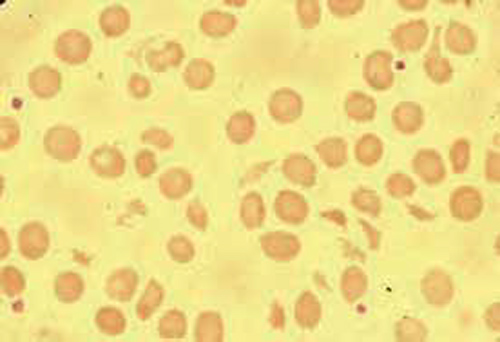

- Pré-requis et Objectifs
-
Cours
-
Contenu
- 1 - Différents types de prothèses valvulaires
- 2 - Physiopathologie
- 3 - Complications des valves cardiaques
- 4 - Surveillance des porteurs de valve cardiaque
- 5 - Pour en savoir plus
- Points essentiels
- Version Enseignants
-
Version PDF

-
Contenu
- Evaluations
- Annexes
- Votre Avis
- Ressources Enseignants
3 - Complications des valves cardiaques
3 . 1 - Complications thrombo-emboliques
- Complications les plus fréquentes des prothèses valvulaires.
- Beaucoup plus fréquentes avec les prothèses mécaniques qu’avec les prothèses biologiques, d’où la nécessité absolue d’un traitement anticoagulant à vie et parfaitement équilibré pour les porteurs de valves mécaniques +++.
- Plus fréquentes dans la première année suivant l’intervention, avant l’endothélialisation de la prothèse, mais le risque persiste au-delà.
- Incidence plus élevée pour les prothèses mitrales (qui fonctionnent à faible pression) que pour les prothèses aortiques.
- Incidence variant également en fonction du type de prothèse : incidence moindre pour les valves à double ailette que pour les modèles plus anciens.
- Favorisées par un traitement anticoagulant insuffisant ++.
Il en existe plusieurs types : embolies systémiques et thromboses de prothèse mécanique.
3 . 1 . 1 - Embolies systémiques
Elles sont dues à la migration d’un thrombus à partir de la prothèse. Elles sont le plus souvent cérébrales (accident ischémique transitoire ou accident vasculaire cérébral constitué, avec parfois séquelles définitives). Plus rarement, il s’agit d’une ischémie aiguë d’un membre, d’infarctus du myocarde par embolie coronaire, d’infarctus rénal ou splénique…
Il s’agit dans ce cas de thromboses non obstructives, n’empêchant pas l’excursion de l’élément mobile, et survenant surtout sur les prothèses mitrales, avec thrombus sur la face atriale de la prothèse en échographie transœsophagienne (ETO).
3 . 1 . 2 - Thromboses de prothèse mécanique
Elles sont à l’origine d’accidents brutaux, avec œdème aigu pulmonaire, ou syncope, ou état de choc, voire mort subite ou très rapide. Il s’agit dans ce cas de thrombose obstructive gênant les mouvements de l’élément mobile (figure 4).
Le diagnostic de thrombose de prothèse est souvent difficile : il existe des modifications de l’auscultation (diminution de l’amplitude des bruits de prothèse ou surtout apparition ou renforcement d’un souffle systolique pour une prothèse aortique ou d’un roulement diastolique pour une prothèse mitrale). Le traitement anticoagulant est souvent insuffisant, il faut rapidement vérifier l’INR.
Le diagnostic est fait par le radio-cinéma de prothèse, sous amplificateur de brillance, qui peut montrer une diminution du jeu des éléments mobiles radio-opaques, et surtout par l’ETT et l’ETO. À l’écho-doppler, les gradients transprothétiques sont anormalement élevés, la surface valvulaire est réduite ; il peut exister une fuite valvulaire par fermeture incomplète de la prothèse. Enfin, le thrombus est parfois visible en ETO.
Une hospitalisation pour réintervention d’urgence est requise pour changement de valve en cas de thrombose aiguë de prothèse (mortalité 30 %).
Dans les formes subaiguës, la thrombolyse donne parfois de bons résultats.
En cas de dysfonction de prothèse de moindre gravité, le traitement anticoagulant doit être rééquilibré avec passage transitoire à l’héparine si nécessaire.
Le diagnostic différentiel (ou l’association) avec l’endocardite bactérienne est parfois difficile d’autant qu’une fébricule est possible dans les thromboses de prothèse.
Figure 4 : Thrombose massive de prothèse de Starr ; thrombus ancien
3 . 2 - Désinsertions de prothèse
Elles surviennent dans 5 % des cas ; surtout durant les premiers mois postopératoires.
Elles sont soit :
- spontanées, par lâchage de sutures sur des tissus fragilisés par des interventions multiples ou des calcifications annulaires ;
- dues à une endocardite infectieuse (EI).
Une désinsertion peu importante, asymptomatique, est suspectée par l’apparition d’un souffle, diastolique pour une prothèse aortique, systolique pour une prothèse mitrale.
Une désinsertion plus importante peut être à l’origine d’une insuffisance cardiaque ou d’une hémolyse : anémie de gravité variable, avec élévation des LDH et présence de schizocytes, ou hématies fragmentées, qui signent le caractère mécanique de l’hémolyse (figure 5).
Le diagnostic est réalisé par l’ETT et surtout par l’ETO : fuite paraprothétique ± importante.
En cas de désinsertion importante, symptomatique, une réintervention peut s’avérer nécessaire.
Figure 5 : Hématies fragmentées ou « schizocytes », dont la présence signe le caractère mécanique d’une hémolyse
3 . 3 - Complications infectieuses
Cf. item 80.
3 . 3 . 1 - Médiastinite postopératoire
Elle survient dans 1 % des cas environ. C’est l’une des principales causes de mortalité précoce.
3 . 3 . 2 - Endocardite infectieuse
C’est une complication redoutable chez les porteurs de prothèse. Ces sujets sont à risque majeur d’endocardite et doivent bénéficier d’une prophylaxie draconienne, et ceci leur vie durant. Le risque d’endocardite est un peu plus élevé sur bioprothèse que sur prothèse mécanique. Il existe des formes précoces et des formes tardives d’endocardite sur prothèse, qui comportent un pronostic différent.
L’endocardite postopératoire précoce est due à une contamination peropératoire par des germes hospitaliers multirésistants, le plus souvent staphylocoques blanc ou doré. Il s’agit d’EI en général aiguë qui se complique de désinsertion de prothèse. Une réintervention précoce est le plus souvent nécessaire. Le pronostic est très sévère (mortalité de l’ordre de 50 %).
L’endocardite tardive (au-delà de 2 mois, 6 mois pour certains) est plus proche de l’endocardite sur valve native avec des germes comparables, mais le staphylocoque est néanmoins en cause dans 50 % des cas. Le pronostic est meilleur que celui de l’EI précoce. La réintervention reste assez souvent nécessaire.
Le diagnostic de l’EI est réalisé à l’aide des hémocultures, de l’ETT et de l’ETO ++ : visualisation des végétations sur la prothèse et des éventuelles complications (désinsertion avec fuite paraprothétique, abcès).
Il faut insister sur la prévention et le traitement indispensable de tout foyer infectieux, notamment ORL et dentaire, chez les porteurs de prothèses ++. En cas de fièvre inexpliquée, il est indispensable de réaliser des hémocultures systématiques, avant toute antibiothérapie prescrite à l’aveugle.
3 . 4 - Complications du traitement anticoagulant
Cf. chapitre 25 – item 182.
Les accidents hémorragiques sont d’autant plus fréquents qu’une hypocoagulabilité importante est nécessaire.
Le risque hémorragique est estimé à 1,2 % années – patients pour les porteurs de valves mécaniques.
Les complications hémorragiques sont de tout type : hémorragie cérébrale, digestive ou hématurie qui doivent faire rechercher une lésion organique sous-jacente, méno-métrorragies, hématome favorisé par un traumatisme. Leur gravité est variable, mais certaines peuvent aboutir au décès.
En cas d’hémorragie sévère, le traitement antivitamine K doit être interrompu, mais le maintien d’une anticoagulation par l’héparine non fractionnée IV est indispensable, en maintenant un TCA de 1,5 à 2 fois le témoin. L’interruption très temporaire du traitement anticoagulant est parfois nécessaire, notamment en cas d’hémorragie intracrânienne.
En cas de grossesse, la problématique est de gérer les AVK, le risque d’accident thrombo-embolique est multiplié par dix. Les complications thrombo-emboliques sont plus fréquentes sous héparine que sous AVK chez les femmes enceintes. Les AVK exposent au risque de fœtopathie. Les AVK doivent être remplacée par l’héparine non fractionnée à dose efficace de la 6e à la 12e semaine puis à partir de la 36e semaine en vue de l’accouchement, ils sont permis de la 12e à la 36e semaine.
3 . 5 - Dégénérescence des bioprothèses
La détérioration tissulaire des bioprothèses est inexorable avec les années, avec apparition de calcifications ou de déchirure, responsables de sténoses et/ou de fuites valvulaires imposant une réintervention.
Dix ans après l’intervention, 70 à 80 % des bioprothèses demeurent fonctionnelles, mais elles ne sont plus que 40 % après 15 ans.
La dégénérescence est d’autant plus rapide que le patient est plus jeune. Outre le jeune âge, la grossesse et l’insuffisance rénale accélèrent également la dégénérescence des bioprothèses.
3/5